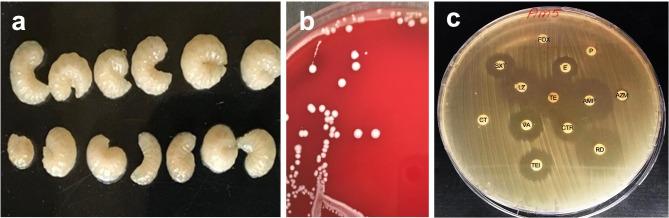
https://cdn.ncbi.nlm.nih.gov/pmc/blobs/949a/10463970/9eb1d1be8084/12864_2023_9590_Fig1_HTML.jpg

对蜜蜂肠道衍生屎肠球菌菌株的毒物耐受基因进行全基因组分析。
Whole genome analyses of toxicants tolerance genes of Apis mellifera gut-derived Enterococcus faecium strains.
机构信息
Department of Botany and Microbiology, Faculty of Science, Alexandria University, Moharam Bek 21511, Alexandria, Egypt.
出版信息
BMC Genomics. 2023 Aug 24;24(1):479. doi: 10.1186/s12864-023-09590-0.
BACKGROUND
Because of its social nature, the honeybee is regularly exposed to environmental toxicants such as heavy metals and xenobiotics. These toxicants are known to exert strong selective pressure on the gut microbiome's structure and diversity. For example, resistant microbial members are more likely to dominate in maintaining a stable microbiome, which is critical for bee health. Therefore, the aim of this study was to examine the Enterococcus faecium strains isolated from bee guts for their in vitro growth and tolerability to diverse heavy metals and xenobiotics. An additional aim was to analyze the genomes of E. faecium isolates to assess the molecular bases of resistance and compare them with E. faecium species isolated from other environmental sources.
RESULTS
The E. faecium bee isolates were able to tolerate high levels (up to 200 mg/L) of toxicants, including cadmium, zinc, benzoate, phenol and hexane. Moreover, the isolates could tolerate toluene and copper at up to 100 mg/L. The genome of E. faecium Am5, isolated from the larval stage of Apis mellifera gut, was about 2.7 Mb in size, had a GC content of 37.9% and 2,827 predicted coding sequences. Overall, the Am5 genome features were comparable with previously sequenced bee-gut isolates, E. faecium Am1, Bee9, SM21, and H7. The genomes of the bee isolates provided insight into the observed heavy metal tolerance. For example, heavy metal tolerance and/or regulation genes were present, including czcD (cobalt/zinc/cadmium resistance), cadA (exporting ATPase), cutC (cytoplasmic copper homeostasis) and zur (zinc uptake regulation). Additionally, genes associated with nine KEGG xenobiotic biodegradation pathways were detected, including γ-hexachlorocyclohexane, benzoate, biphenyl, bisphenol A, tetrachloroethene, 1,4-dichlorobenzene, ethylbenzene, trinitrotoluene and caprolactam. Interestingly, a comparative genomics study demonstrated the conservation of toxicant resistance genes across a variety of E. faecium counterparts isolated from other environmental sources such as non-human mammals, humans, avians, and marine animals.
CONCLUSIONS
Honeybee gut-derived E. faecium strains can tolerate a variety of heavy metals. Moreover, their genomes encode many xenobiotic biodegradation pathways. Further research is required to examine E. faecium strains potential to boost host resistance to environmental toxins.
背景
由于其社会性,蜜蜂经常接触到重金属和外来生物等环境毒物。这些毒物已知对肠道微生物组的结构和多样性产生强烈的选择性压力。例如,具有抗性的微生物成员更有可能在维持稳定的微生物组中占主导地位,这对蜜蜂的健康至关重要。因此,本研究的目的是研究从蜜蜂肠道中分离出的屎肠球菌菌株在体外对各种重金属和外来生物的生长和耐受性。另一个目的是分析屎肠球菌分离株的基因组,以评估抗性的分子基础,并将其与从其他环境来源分离出的屎肠球菌物种进行比较。
结果
屎肠球菌蜜蜂分离株能够耐受高水平的毒物(高达 200mg/L),包括镉、锌、苯甲酸、苯酚和己烷。此外,分离株还能耐受高达 100mg/L 的甲苯和铜。从蜜蜂幼虫肠道中分离出的屎肠球菌 Am5 的基因组大小约为 2.7Mb,GC 含量为 37.9%,预测有 2827 个编码序列。总体而言,Am5 基因组的特征与先前测序的蜜蜂肠道分离株屎肠球菌 Am1、Bee9、SM21 和 H7 相似。蜜蜂分离株的基因组为观察到的重金属耐受性提供了线索。例如,存在重金属耐受和/或调节基因,包括 czcD(钴/锌/镉抗性)、cadA(ATP 出口酶)、cutC(细胞质铜稳态)和 zur(锌摄取调节)。此外,还检测到与 9 个 KEGG 外来生物生物降解途径相关的基因,包括γ-六氯环己烷、苯甲酸、联苯、双酚 A、四氯乙烯、1,4-二氯苯、乙苯、三硝基甲苯和己内酰胺。有趣的是,比较基因组学研究表明,来自非人类哺乳动物、人类、鸟类和海洋动物等其他环境来源的多种屎肠球菌对应物的毒物抗性基因是保守的。
结论
蜜蜂肠道衍生的屎肠球菌菌株可以耐受多种重金属。此外,它们的基因组编码许多外来生物生物降解途径。需要进一步研究屎肠球菌菌株增强宿主对环境毒素的抗性的潜力。